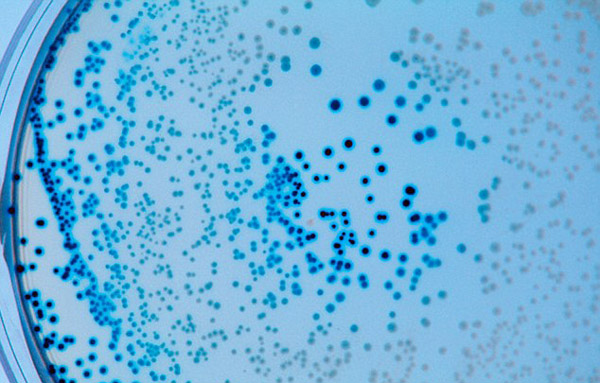

经济学家预测2050年全球约1000万人将死于超级细菌感染
2014年12月12日 14:14
来源:国际在线
国际在线专稿:据英国《每日邮报》12月11日报道,经济学家吉姆·奥尼尔(Jim O'Neill)日前公布首份《抗菌素耐药性评估报告》。其中警告称,超级细菌每年已经导致全球成千上万人死亡,如果不采取紧急措施,这种趋势将更加恶化。他预测,到2050年,全球每年将有1000万人因感染超级细菌死亡,经济损失高达100万亿美元(约合人民币619万亿元)。
许多细菌已经展现出令人担忧的抗药性迹象,包括大肠杆菌。(网页截图)
网罗天下

凤凰资讯官方微信
图片新闻
视频
-
李咏珍贵私人照曝光:24岁结婚照甜蜜青涩
播放数:145391
-
金庸去世享年94岁,三版“小龙女”李若彤刘亦菲陈妍希悼念
播放数:3277
-
章泽天棒球写真旧照曝光 穿清华校服肤白貌美嫩出水
播放数:143449
-
老年痴呆男子走失10天 在离家1公里工地与工人同住
播放数:165128


